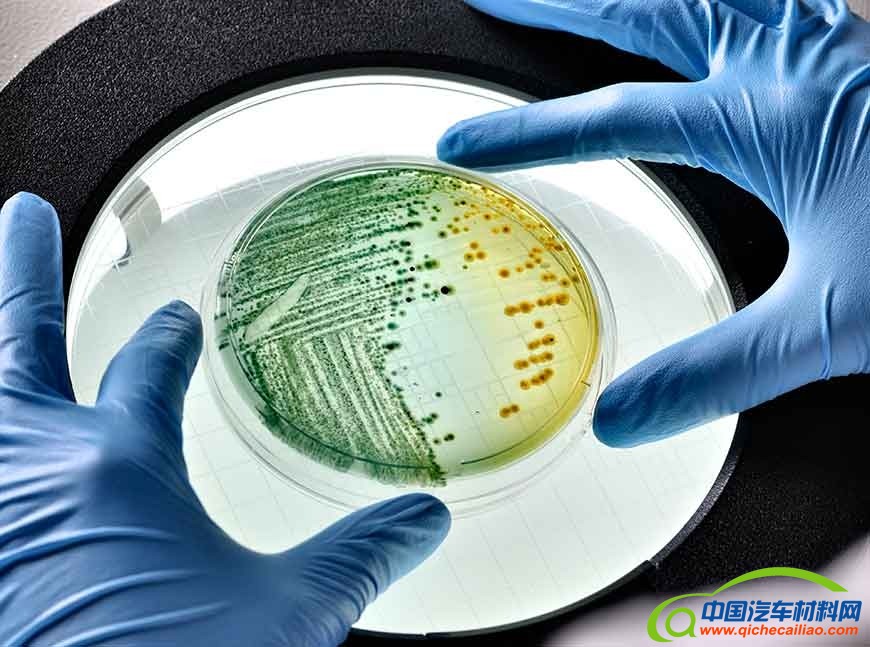

除了可能引起异味问题外,这些微生物还可能对成品塑料零件的美观和机械性能造成不良变化。高接触表面和应用特别容易受到影响。为此,Avient开发了含有抗菌添加剂的GLS™ TPE——Versaflex™ 和OnFlex™ 系列。潜在的应用包括消费电子产品、个人护理用品的握把和汽车应用,如杯托垫和暖通空调密封件等。
含有抗菌添加剂的GLS™ TPE可以帮助延长产品的使用寿命,从而减少其更换次数。额外的好处包括保持表面完整性,增加耐用性,减少异味,以提供更好的消费者体验。
“现在可以用TPE设计产品,通过抑制微生物生长来延长使用寿命,”Avient专业工程材料全球营销总监Matt Mitchell说,“这些新配制的材料还具有我们GLS™ TPE的同义性能。”
经过对常见微生物的测试,含有抗菌添加剂的GLS™ TPE被证明可以保护成品部件在纹理和光滑表面不受微生物的影响。它们是由微生物控制解决方案的可靠领导者Lonza LLC提供的经EPA注册的抗菌剂配制而成。这种添加剂的化学成分与几十年来用于个人护理产品(如去屑洗发水)的添加剂相同。
含有抗菌添加剂的GLS™ TPE已在美国和亚洲上市。其他含有抗菌剂的配方正在开发中。







